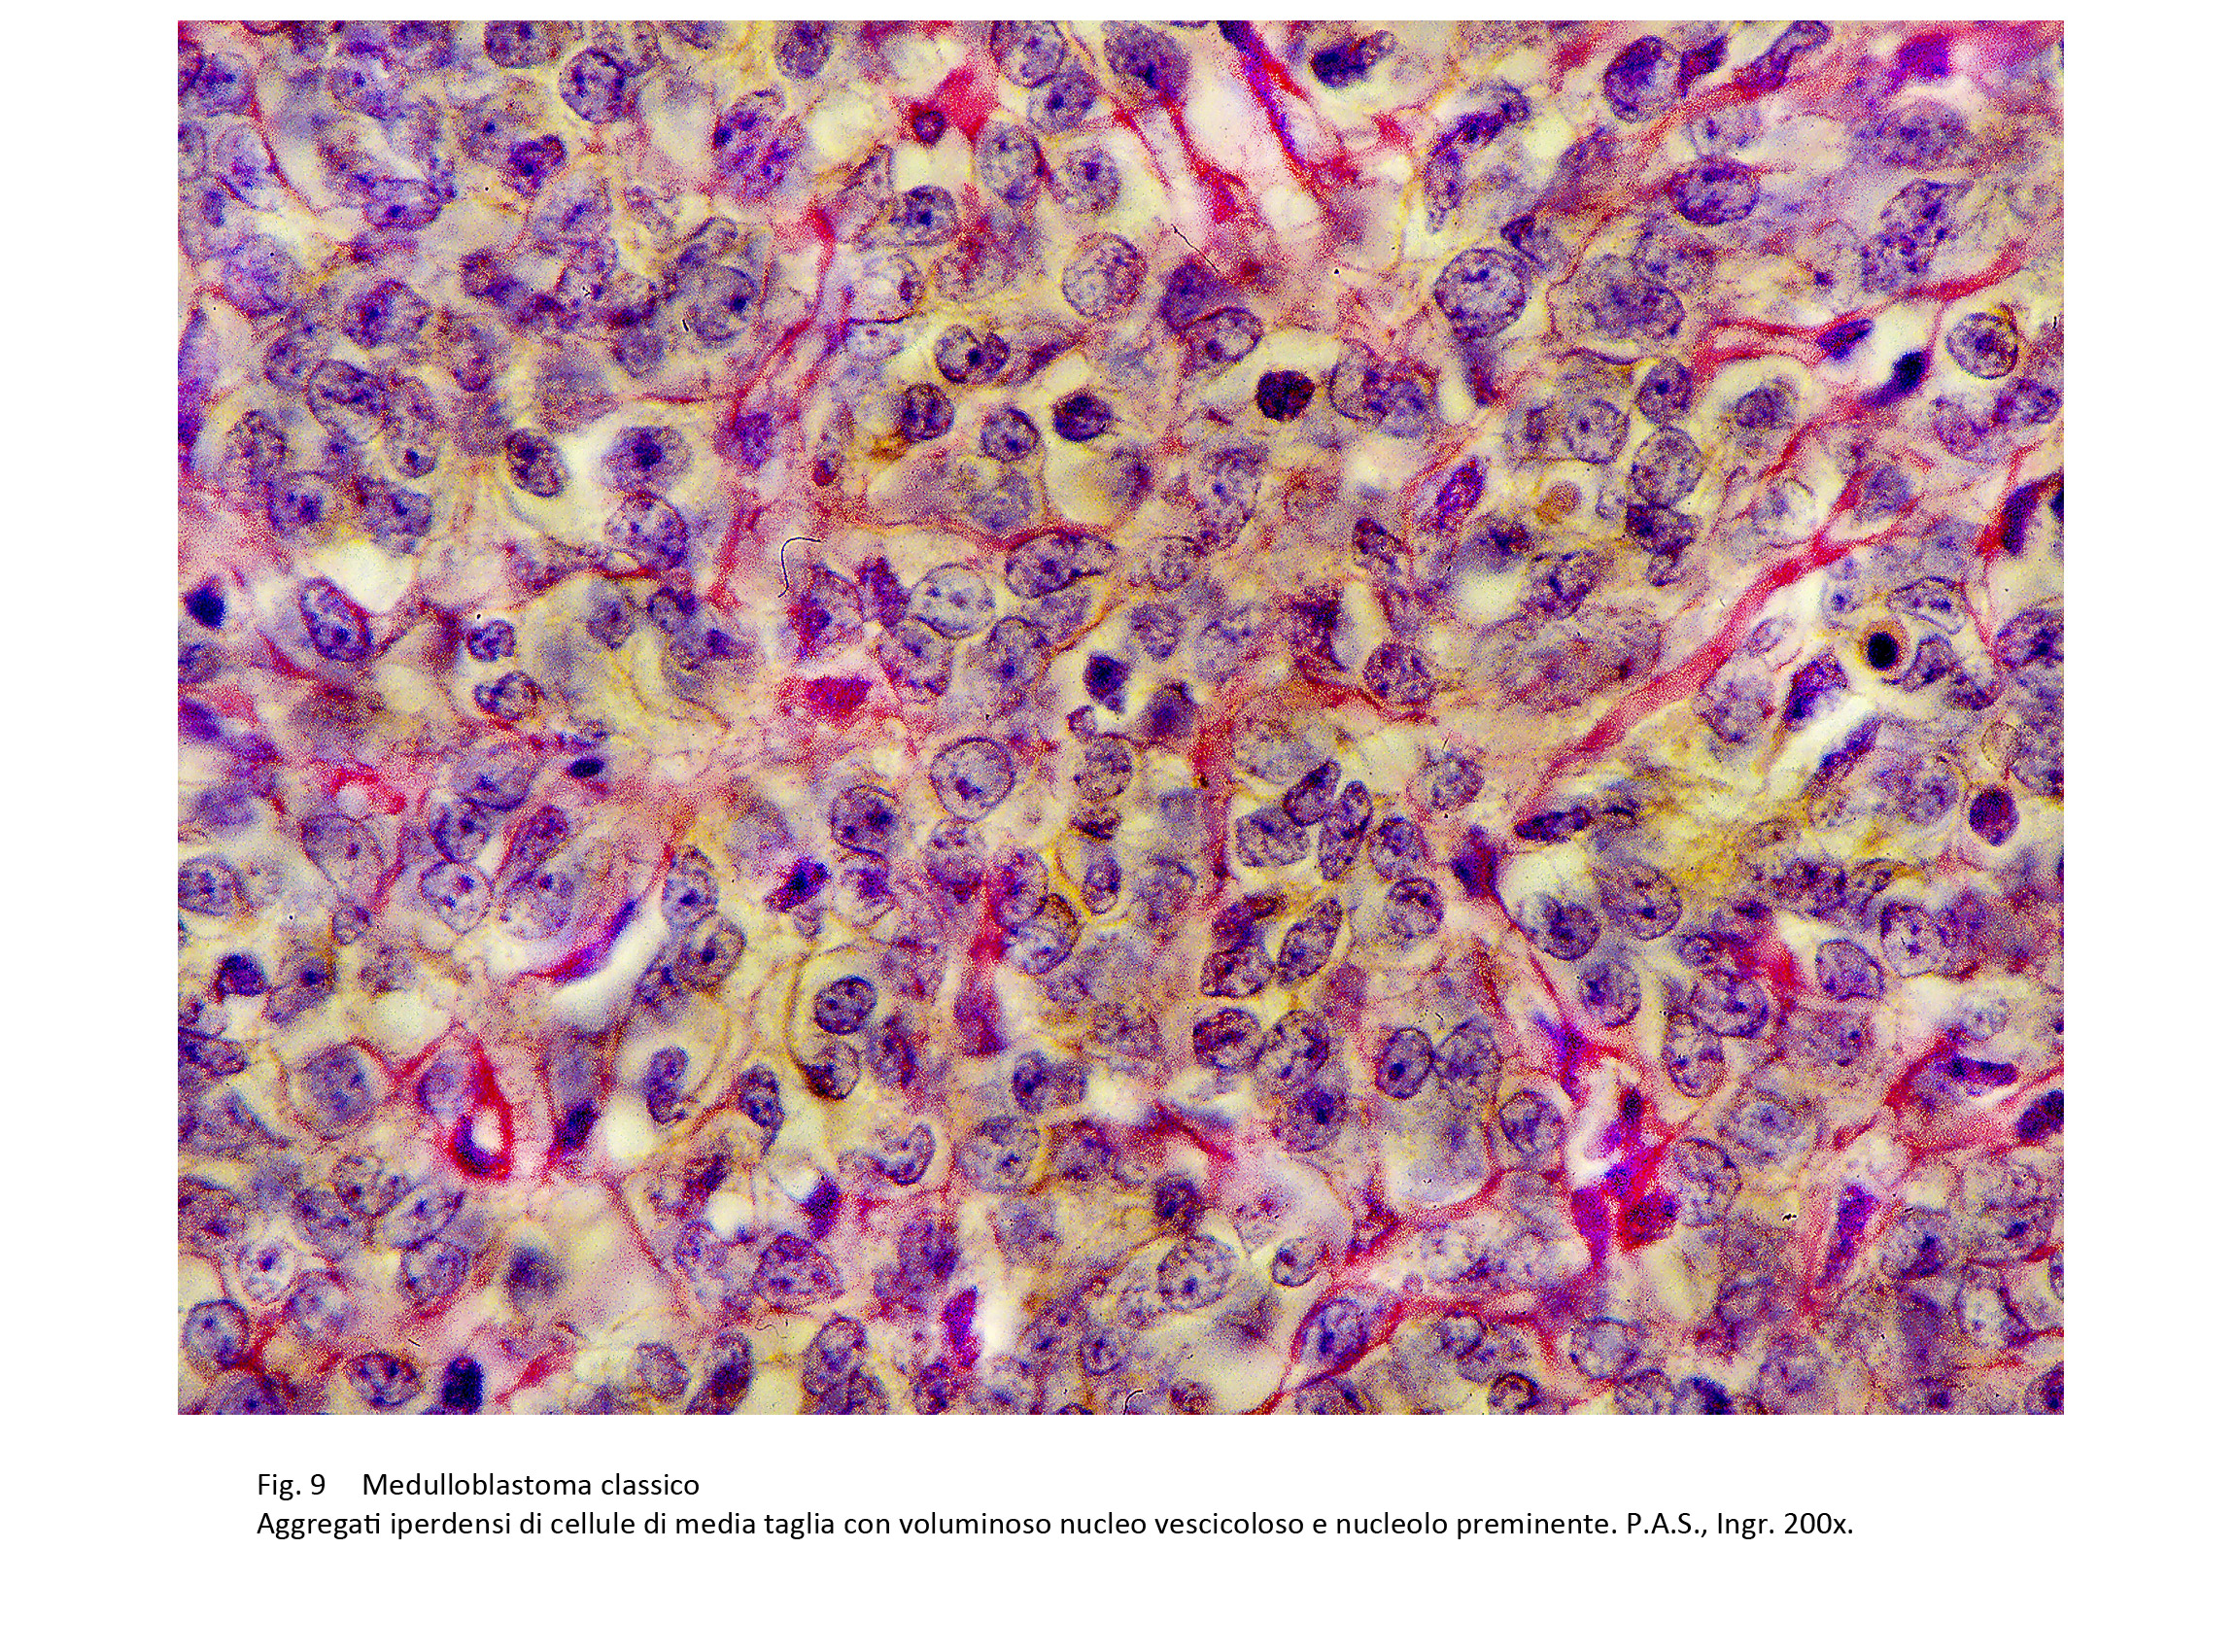

MEDULLOBLASTOMA
Luigi Cuccurullo
|
Il medulloblastoma è un tumore embrionale del cervelletto, con differenziazione in senso neurale. Esso è altamente invasivo,e si manifesta con prevalente incidenza nell’età infantile (W.H.O.)
Abitualmente ha origine a livello del verme cerebellare, ma con una minore frequenza si può manifestare primariamente anche a carico degli emisferi cerebellari.
Si accresce con modalità infiltrative,nel suo sviluppo invade la cavità del 4° ventricolo, penetra nella corteccia cerebrale, occupa gli spazi sub-arcnoidei e le leptomeningi.
All’esame macroscopico questo tumore si rivela molle, friabile, a margini indistinti; al taglio, evidenzia un colore grigio-rossastro o variegato per la presenza di focolai emorragici e/o di aree di necrosi.
Frequentemente il medulloblastomia che origina dagli emisferi cerebellari evidenzia, all’esame macroscopico, un aspetto compatto, una consistenza parenchimatosa, un colore uniformemente grigiastro per assenza di processi necrotico-emorragici.
Lo studio istopatologico ha permesso di evidenziare i seguenti tipi morfologici e su tali basi è stata redatta la seguente classificazione (WHO) :
Medulloblastoma classico
Medulloblastoma desmoplastico nodulare
Medulloblastoma a nodularità estesa
Medulloblatoma anaplastico
Medulloblastoma a larghe cellule
Il Medulloblastoma classico è un tumore ad alta densità cellulare, caratterizzato da un elevato indice proliferativo come si evidenzia anche dal riscontro di numerose mitosi tipiche ed atipiche. La sua micro-architettura presenta aspetti diversificati nei vari casi o da zona a zona nello stesso reperto anatomico.
Viene descritta una varietà diffusa nella quale le cellule si ammassano in modo casuale e informe; nel contesto di tali aggregati cellulari si possono repertare con frequenza cellule disposte circolarmente a disegnare le rosette di Homer-Wright.
fig.1  fig.2
fig.2  fig3
fig3
fig.4  fig.4b
fig.4b  fig.5
fig.5 
Una secanda varietà è data da elementi medulloblastici disposti in filiere parellele , separate da sottili tralci fibrillari. Questa variante è composta quasi sempre da elementi di piccola taglia, altamente indifferenziati, di forma rotondeggiante od ovolare;essi mostrano un esiguo orletto di citoplasma e sono centrati da un grosso nucleo, ipercromatinico, compatto e con un nucleolo visibile con difficoltà. Queste cellule rivelano un indice di coesione intercellulare molto basso o nullo; infatti esse tendono a dissociarsi fino a ritrovarsi isolate e disperse negli spazi interstiziali.
fig.6 fig.7
fig.7
E’ riportata in letteratura una terza varietà in cui le cellule hanno una microarchitettura a cordoni, o a travate tra loro correlati in modo da far emergere un disegno a rete.
In questi casi la popolazione cellulare è di media grandezza, evidenzia una maggiore quota di citoplasma ed è fornita di un grosso nucleo vescicoloso, con nucleolo preminente,con possibilità di profili dismorfi o “bizzarri”.Nel contesto di tale variante sono presenti anche quote cellulari con caratteri polimorfi ,irregolari e con un una proiezione“polare”.
fig.8 fig.9
fig.9 fig.10
fig.10
In sintesi, emerge una stretta correlazione tra i livelli di differenziazione delle cellule, gli indici della attività mitotica, il polimorfismo cellulare e il grado di organizzazione della neoplasia.
Anche l’assetto stromale rientra in questa correlazione; infatti nei casi di medulloblastoma altamente indifferenziato, la quota stromale è presente solo in sede perivascolare e la popolazione cellulare è ammassata in modo diffuso e priva di supporto fibrillare.
fig.11 fig.12
fig.12
Nei casi in cui si riscontra un inizio di differenziazione delle cellule con una organizzazione pseudonodulare della neoplasia, la composizione stromale si sviluppa secondo una doppia morfologia: la prima è costituita da tralci connettivali che sepimentano in modo irregolare le aree pseudonodulari la seconda è formata da una delicata rete di fibrille pre-collagene che incestella le cellule neoplastiche singolarmente o a piccoli gruppi.
fig.13 fig.14
fig.14
Anche la componente vascolare è ben sviluppata; essa è ben strutturata ma è distribuita in modo irregolare,e asimmetrico; in alcuni campi si rilevano aggregazioni vascolari tra loro quasi a mutuo contatto, fornendo così immagini di pseudoangioma. Abitualmente i vasi sono avvolti da filiere di cellule neoplastiche e queste, nel loro proliferare, infiltrano le pareti dei vasi e si riversano nel torrente circolatorio.
fig.15 fig.16
fig.16
fig.17 fig.18
fig.18
Medulloblastoma desmoplastico nodulare
Il medulloblastoma desmoplastico nodulare è caratterizzato, al microscopio luce, da noduli di varia grandezza, disposti in modo ravvicinato e tenuti assieme da tralci fibrillari. Ciascun nodulo è formato da un’area centrale ipercellulata la quale è demarcata da uno spesso cercine periferico di stroma fibroso.
La prima (l’area centrale) è occupata da una densa popolazione cellulare con scarsa coesione intercellulare e disposta in modo diffuso. Questi elementi sono in maggioranza monomorfi, di piccola taglia; questo monomorfismo è frequentemente diluito dalla presenza di piccole quote di cellule di varia grandezza e pleomorfe.
fig.19
Tale popolazione cellulare è priva di supporto stromale ,rintracciabile solo in sede perivascolare. La seconda (il cercine periferico) è costituito da fascicoli fibrillari collagene e precollagene i quali contengono negli spazi interstiziali filiere e microfoci di cellule neoplastiche.
Le zone internodulari sono occupate da una popolazione medulloblastica variamente disposta e sostenuta da una rete di fibrille reticolari e da tralci di fibre collagene. La componente vascolare è ben rappresentata ed è più sviluppata a livello dei cercini periferici rispetto alle aree indifferenziate centrali.
fig.20
Medulloblastoma a nodularità estesa
Questa variante di medulloblastoma è caratterizzata dalla presenza di noduli ampi, numerosi, e di conseguenza disposti quasi a mutuo contatto; gli spazi tissutali internodulari sono ridotti o quasi nulli.
Ciascuna unità nodulare è formata da un’ampia area centrale, la quale è delimitata da una sottile fascia tissutale disposta alla periferia. L’area centrale è occupata da una densa popolazione cellulare la quale è disposta in modo compatto costituendo aggregati informi; essa non è sostenuta da strutture fibrillari sebbene sia permeata da numerosi vasi. La fascia periferica è data da tralci fibrillari di vario spessore i quali sono dissociati e infiltrati da cellule neoplastiche.
Gli spazi internodulari sono occupati da aggregati di cellule medulloblastiche, disposti in varia maniera e supportati da una rete fibrillare precollagene con la presenza di rari tralci di fibre collagene.
Questa variante di medulloblastoma è caratterizzata da cellele pleomorfe con diversi gradi di differenziazione con il possibile riscontro di elementi maturativi orientati verso i neurociti o verso gli astrociti.
Medulloblastoma anaplastico
Il medulloblastoma anaplastico è costituito dalla presenza di elementi indifferenziati di varia grandezza e marcato pleomorfismo cellulare; questi elementi sono privi di coesione intercellulare, evidenziano una elevata attività mitotica e subiscono frequenti processi regressivi e necrotici.
Un esame dettagliato dei reperti mette in evidenza la co-esistenza di focolai cellulari con gradi diversi di differenziazione (aspetti non anaplastici) e la presenza di cellule differenziate in senso medullo-mioblastico.
Nei casi in cui il polimorfismo cellulare è molto elevato, è necessario (per una corretta diagnosi di medulloblastoma anaplastico) procedere a una valutazione semiquantitativa del reperto operatorio, per accertare la preminenza della componente anaplastica.
Medulloblastoma a larghe cellule
Il medulloblastoma a larghe cellule è formato dalla presenza di elementi voluminosi aventi una scarsa o nulla coesione intercellulare e privi di ogni organizzazione strutturale; essi si distribuiscono in modo casuale e possono coesistere anche con focolai di medulloblastoma desmoplastico, di medulloblastoma anaplastico, o di focolai di medullomioblastoma. Gli elementi che compongono questa neoplasia hanno ampio citoplasma eosinofilo e sono occupati da nuclei vescicolosi con nucleolo preminente; essi sono frequentemente in mitosi e possono presentare processi di apoptosi.
fig.21 fig.22
fig.22
fig.23 fig.24
fig.24
La componente stromale è esigua oppure assente e ciò favorisce il disordine strutturale con assenza di ogni disegno architettonico. Nel contesto di questa popolazione a larghe cellule si può repertare la co-presenza di elementi di piccola e media taglia con i caratteri di elementi altamente indifferenziati. La popolazione cellulare di questa neoplasia frequentemente subisce processi di degenerazione o di lisi citoplasmatica .
Medullomioblastoma
Il medullomioblastoma è un istotipo caratterizzato dalla presenza, in quantità variabili, di cellule aventi i caratteri dei rabdomioblasti. Questi elementi si ritrovano in stretta commistione con quote cospicue di elementi medulloblastici classici o di elementi a larghe cellule.
La diagnosi di certezza richiede indagini coordinate di microscopia luce, di immunoistochimica e di microscopia elettronica.
Con la microscopia luce, applicando metodi speciali, si ricerca la presenza delle specifiche striature delle fibre muscolari. Mediante le indagini di immunoistochimica si ricercano livelli di immunoespressività positivi per la mioglobina e per la desmina. Con il supporto della microscopia elettronica sarà possibile mettere in evidenza strutture riconoscibili come sarcomeri.
Medulloblastoma melanotico
Il medulloblastoma melanotico è una variante identificabile per la presenza di cellule neuroectodermiche con citoplasma carico di melanina.
La neoplasia è pleomorfa per la presenza di quote cospicue di cellule medulloblastiche classiche e/o di strutture identificabili come medulloblasti desmoplastici.
Profilo immunoistochimico dei medulloblastomi
La immunoespressività delle cellule del medulloblastoma è sostanzialmente connessa agli orientamenti e ai livelli di differenziazione delle cellule.
Se questi elementi presentano processi di differenziazione in senso neuronale si riscontrano positività per la NSE e per la Sinaptofisina e per la Cromogranina; se i fenomeni maturativi sono orientati in senso astrocitario le cellule rivelano una immunoespressività per la GFAP.
fig.25
Il grado di immunoespressività di questi antigeni è conseguente sia ai livelli di differenziazione delle cellule, sia alla loro consistenza numerica, sia ancora alla integrità della morfologia cellulare poichè processi regressivi, necrotici, flogistici, emorragici condizionano negativamente la espressività immunologica.
La lettura dei dati deve escludere il rischio di false positività per la presenza di cellule neuronali o gliali rimaste intrappolate nella massa neoplastica.
Caratteri ultrastrutturali dei medulloblastomi
La microscopia elettronica consente di documentare le cellule medulloblastiche indifferenziate e di cogliere i diversi livelli di diffferenziazione delle stesse attraverso lo sviluppo delle sub-strutture e i prolungamenti del citoplasma.
Le cellule indifferenziate o scarsamente differenziate mostrano, al microscopio elettronico, nel loro esiguo citoplasma pochi mitocondri, rade strutture ergastoplasmatiche, molti ribosomi dispersi e quote cospicue di glicogeno. Le loro superfici sono prive di prolungamenti citoplasmatici e la coesione intercellulare non è rafforzzata e sostenuta da strutture giunzionali.
fig.26 fig.27
fig.27 fig.28
fig.28
Frequentemente si riscontrano cellule simili alle precedenti ma con un livello maturativo più avanzato;questa valutazione è sostenuta dalla presenza, in
un’area circoscritta del citoplasma, di gruppi di mitocondri,di numerose strutture ergastoplasmatiche e di ben sviluppati campi golgiani.
fig.29 fig.30
fig.30 fig.31
fig.31
Il grado di differenziazione delle cellule viene letto ed interpretato seguendo lo sviluppo sempre crescente degli organuli del citoplasma, dei livelli della coesione intercellulare e dalla presenza di strutture giunzionali. Infatti, è possibile rilevare una organizzazione citoplasmatica sempre più complessa con quote sempre più elevate di mitocondri, di ergastoplasma, di campi golgiani e con la comparsa di sub-strutture giunzionali.
fig.32 fig.33
fig.33 fig.34
fig.34
fig.35 fig.36
fig.36 fig.37
fig.37
fig.38 fig.39
fig.39
In alcuni campi le cellule medulloblastiche tendono a disporsi circolarmente in modo da delimitare uno spazio cavo non apprezzabile al microscopi luce; questo spazio può essere privo di contenuti oppure può essere occupato in modo parziale o globale da prolungamenti citoplasmatici; in altri casi per la proliferazione delle cellule componenti e in conseguenza dei processi di differenziazione delle stesse, può accrescersi in modo anomalo distorcendosi e provocando una decoesione delle cellule con possibili processi regressivi e citolitici.
fig.40 fig.41
fig.41
fig.42 fig.43
fig.43
In molti casi si rileva che anche gli spazi intercellulari con diversi gradi di ampliamento sono occupati da prolungamenti citoplasmatici.
fig.44 fig.45
fig.45
fig.45b  fig.46
fig.46
Il processo maturativo in senso neuronale si concretizza e si evidenzia per il riscontro a livello ultrastrutturale di corpi multivescicolosi, di microtubuli dendritici, di proiezioni dendritiche e di bottoni sinaptici.
fig.47 fig.48
fig.48 fig.48b
fig.48b
fig.49 fig.50
fig.50 fig.51
fig.51

